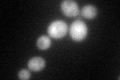
YLR262C-A
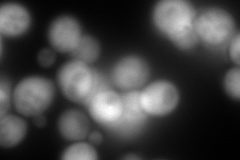
YLR262C-A
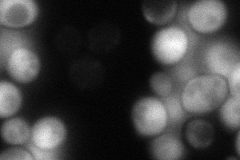
YLR262C-A
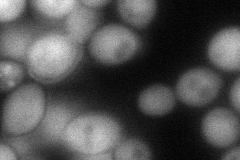
YLR262C-A
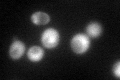
YLR262C-A
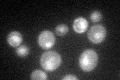
YLR262C-A

View description
Protein of unknown that associates with ribosomes; null mutant exhibits translation defects, altered polyribosome profiles, and resistance to the translation inhibitor anisomcyin
Localization:
Intensity:
Fold change:
Significance:
-
C’ GFP library in SD
cytosol94.47 -
N' NOP1pr-GFP in SD

cytosol441.574 -
N' TEF2pr-mCherry in SD
cytosol785.76 -
N' NATIVEpr-GFP in SD
cytosol88.6803 -
N' TEF2pr-VC and Cyto-VN in SD
cytosol89.4128 -
C’ GFP library in SD+DTT

cytosol92.940.98No -
C’ GFP library in SD+H2O2
cytosol98.851.04No -
C’ GFP library in Starvation Media
nucleusN/AN/AYes -
C’ GFP library on the background of Pup2-DaMP

cytosol -
C’ GFP library on the background of CCT mutant

cytosol85.97360.909934No
